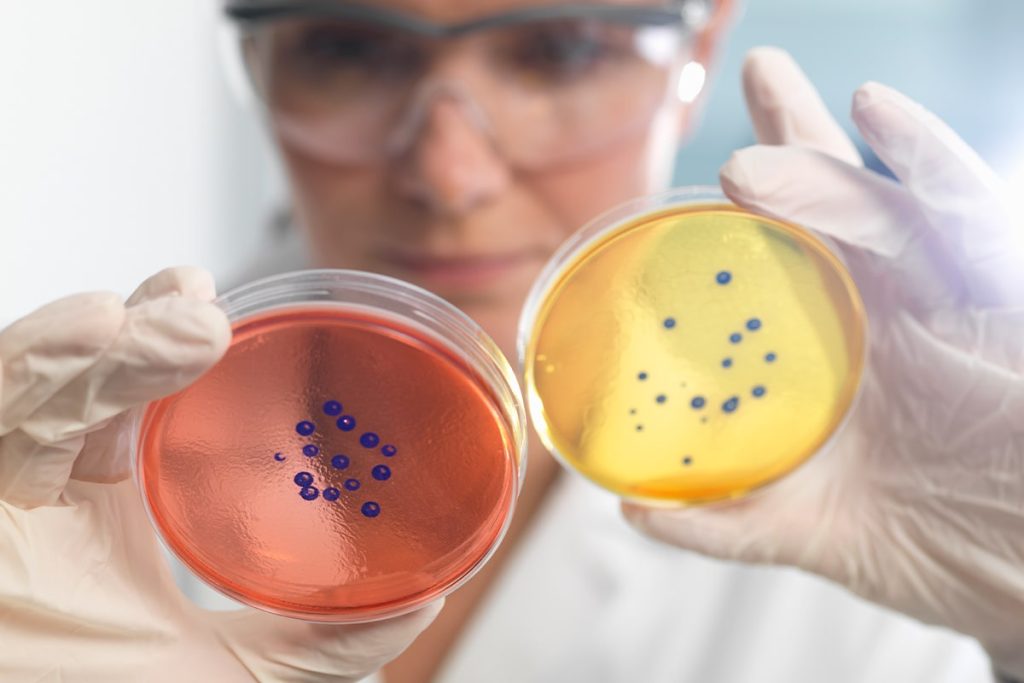

Comprehensive Private Blood Tests for Personalised Health Screening and Early Detection
At Bids Chemist, we offer reliable and private blood testing services in Norbury, Thornton Heath, Streatham Vale, or Croydon to help you take control of your health. Our expert team provides fast, accurate results covering everything from allergy and hormone testing to heart and kidney function assessments. Whether you’re monitoring ongoing conditions or seeking peace of mind, our health screening services ensure proactive care and personalised guidance.
To complete your booking, please select your test, copy the relevant test code, and paste it into the code field on the booking form. You can browse all test codes here.
Allergy blood tests help identify what’s causing reactions such as sneezing, rashes, or stomach discomfort.
Accurate, Affordable and Convenient Health Testing by Trusted Professionals Near You
Bids Chemist makes private health testing simple and stress-free. Our comprehensive range of diagnostic blood tests helps identify key health markers, nutritional deficiencies, and underlying issues before they become serious. Begin your journey towards better health and wellbeing with our private blood testing services in Norbury, Thornton Heath, Streatham Vale, or Croydon.